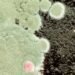
Aspergillosis Explained: Types, Symptoms, and Who's at Risk

Lead paint is a common feature in many homes, especially those built before 1978. While lead paint is not necessarily harmful if it remains intact, it can become a significant health hazard if it begins to deteriorate or is disturbed during renovation, repair, or painting. As such, it is essential for homeowners to be aware of the risks associated with lead paint and to take the necessary precautions to ensure the safety of their families and their homes.

This comprehensive guide to lead paint safety for homeowners provides a detailed overview of everything you need to know about detecting, removing, and protecting against lead paint in your home. From the history and regulations surrounding lead paint to the health risks associated with exposure, the guide covers all the essential information you need to keep your family safe. It also includes detailed information on detection methods, safe removal and abatement strategies, and prevention and maintenance techniques to ensure that your home remains lead-free over the long term.
Key Takeaways
- Homeowners should be aware of the risks associated with lead paint and take necessary precautions to ensure the safety of their families and homes.
- Detection, safe removal and abatement strategies, and prevention and maintenance techniques are essential for keeping your home lead-free.
- Compliance with legal responsibilities, tenant rights, and the Renovation, Repair, and Painting Rule is critical to avoiding legal and financial issues related to lead paint.
History and Regulations of Lead Paint

Lead paint has been used in homes for centuries due to its durability and ability to dry quickly. However, it wasn’t until the 20th century that the harmful effects of lead exposure were discovered. Today, the use of lead paint in homes is heavily regulated, and homeowners need to be aware of the laws and regulations in place to keep themselves and their families safe.
Lead Paint Use in Homes
Lead paint was commonly used in homes until the 1970s, and it can still be found in older homes today. Lead-based paint is especially dangerous when it begins to chip or peel, as the lead can be ingested or inhaled. Children are particularly vulnerable to lead exposure, as their developing bodies absorb more lead than adults.
The 1978 Ban and Its Impact
In 1978, the United States government banned the use of lead-based paint in residential properties. This ban has had a significant impact on the prevalence of lead exposure in homes, but it is important to note that many older homes still contain lead-based paint. Homeowners should be aware of the age of their home and any potential risks associated with lead-based paint.
EPA and Federal Lead Regulations
The Environmental Protection Agency (EPA) is responsible for enforcing federal lead regulations. The EPA’s Lead Renovation, Repair, and Painting Rule (RRP) requires contractors to take specific precautions when working on homes built before 1978, including testing for lead-based paint, containing the work area, and properly disposing of lead-contaminated materials. Homeowners should be aware of these regulations when hiring contractors to work on their homes.
In addition to federal regulations, many states and local governments have their own laws regarding lead paint. Homeowners should research the laws in their area and take appropriate steps to protect themselves and their families from lead exposure.
Health Risks and Lead Exposure
Exposure to lead, especially for children, can have serious health implications. Lead is a toxic metal that can harm almost every organ in the human body. In this section, we will discuss the effects of lead on children and adults, lead poisoning symptoms, and long-term health implications.
Effects of Lead on Children and Adults
Children and adults can be affected by lead exposure. However, children are more vulnerable to lead poisoning than adults because their brains and bodies are still developing. Exposure to lead can cause damage to the brain and nervous system, slow growth and development, and cause learning and behavior problems in children. In adults, lead exposure can cause high blood pressure and damage to the reproductive system.
Lead Poisoning Symptoms
Lead poisoning symptoms can vary depending on the level of exposure and the age of the person exposed. Symptoms in children can include anemia, stomach pain, constipation, learning difficulties, and seizures. In severe cases, lead poisoning can lead to coma and death. Symptoms in adults can include high blood pressure, joint and muscle pain, memory loss, and mood disorders.
Long-Term Health Implications
Long-term exposure to lead can have serious health implications. In children, lead exposure can cause permanent damage to the brain and nervous system, resulting in learning difficulties, behavioral problems, and decreased IQ. In adults, long-term exposure to lead can cause high blood pressure, heart disease, kidney damage, and reproductive problems.
It is important to note that lead poisoning is preventable. Homeowners can take steps to protect themselves and their families from lead exposure by having their homes tested for lead, hiring a certified professional to remove lead-based paint, and taking precautions when renovating or remodeling older homes.
Detection of Lead in Your Home
Lead-based paint is a common problem in older homes, and it can be hazardous to your health. If you suspect that your home may contain lead-based paint, it’s important to take action to protect yourself and your family.
Identifying Lead-Based Paint
Lead-based paint was commonly used in homes built before 1978. If your home was built before this time, there is a good chance that it contains lead-based paint. However, it can be difficult to identify lead-based paint just by looking at it.
One way to identify lead-based paint is to check for its characteristic properties. According to the Environmental Protection Agency (EPA), lead-based paint is typically:
- Thick and pasty when wet
- Dries to a rock-hard consistency
- Often has a sweet odor
- Comes in a limited range of colors, such as white, gray, and brown
Testing for Lead Contamination
If you suspect that your home may contain lead-based paint, it’s important to have it tested for lead contamination. There are a few different methods for testing for lead contamination, including:
- Lead check swabs
- X-ray fluorescence (XRF) testing
- Laboratory analysis of paint chips and dust samples
Interpreting Test Results
If your home tests positive for lead contamination, it’s important to take action to protect yourself and your family. The California Department of Public Health recommends taking the following steps:
- Hire a certified lead abatement contractor to remove the lead-based paint
- Keep children and pregnant women away from the area until the lead-based paint has been removed
- Clean up any dust or debris from the area using a wet cloth or mop
- Monitor your family’s blood lead levels
If your home tests negative for lead contamination, it’s still important to take steps to prevent lead exposure. The EPA recommends regularly cleaning your home to remove any dust or debris that may contain lead. You should also avoid using abrasive cleaning methods, such as sanding or dry scraping, as these can release lead particles into the air.
Safe Removal and Abatement Strategies
Lead paint removal and abatement are essential processes to ensure that homes are safe from lead hazards. Homeowners must be aware of the different options available to them for lead paint removal and abatement. This section discusses the different strategies that homeowners can use to safely remove and abate lead paint.
Lead Paint Removal Options
There are several options available for removing lead paint. These include wet scraping, heat stripping, and chemical stripping. Wet scraping involves using a scraper and water to remove the paint. Heat stripping involves using a heat gun to soften the paint, making it easier to remove. Chemical stripping involves using a chemical solution to dissolve the paint.
It is important to note that lead paint removal can create a significant amount of dust and debris. To prevent lead exposure, homeowners must use lead-safe work practices when removing lead paint. This includes using personal protective equipment, containing the work area, and properly disposing of debris.
Lead Abatement Procedures
Lead abatement is a process that permanently eliminates lead hazards. The most common abatement procedures include removing lead paint, encapsulating surfaces that contain lead paint, and replacing building components that contain lead.
Removing lead paint involves physically removing the paint from surfaces. Encapsulating surfaces involves applying a coating over the lead paint to prevent it from chipping or peeling. Replacing building components involves removing and replacing components that contain lead, such as windows or doors.
Homeowners should choose the most effective abatement method that creates the least hazard. It is important to note that lead abatement procedures can create hazardous debris and can be labor-intensive. Homeowners should consider hiring a qualified contractor to perform lead abatement.
Choosing a Qualified Contractor
When choosing a contractor to perform lead abatement, homeowners should ensure that the contractor is qualified and experienced in lead abatement procedures. Homeowners should ask for references and check the contractor’s certifications and licenses.
Homeowners should also ensure that the contractor uses lead-safe work practices and follows all applicable regulations and guidelines. Homeowners should obtain a written contract that outlines the work to be performed, the timeline, and the cost.
In summary, homeowners have several options available for removing and abating lead paint. It is important to use lead-safe work practices and to choose a qualified contractor to perform lead abatement procedures. By following these guidelines, homeowners can ensure that their homes are safe from lead hazards.
Renovation, Repair, and Painting Rule
Understanding the RRP Rule
The Renovation, Repair, and Painting (RRP) Rule was established by the Environmental Protection Agency (EPA) to protect homeowners and their families from lead-based paint hazards that may be present during renovation, repair, or painting activities. The rule requires that firms and contractors performing such activities in pre-1978 homes, child-occupied facilities, and schools must be certified by the EPA and follow lead-safe work practices to minimize the risk of lead exposure.
The RRP Rule applies to activities that disturb more than six square feet of interior painted surfaces or 20 square feet of exterior painted surfaces. It also applies to window replacement and any activity that involves cutting, sanding, or demolition of painted surfaces. Homeowners who perform these activities themselves are exempt from the rule but are still encouraged to follow lead-safe work practices.
Compliance and Safety During Renovations
Compliance with the RRP Rule involves several steps to ensure the safety of workers and occupants during renovations. First, firms and contractors must obtain EPA certification by submitting an application and completing an accredited training course. Second, they must follow lead-safe work practices that include containing the work area, minimizing dust and debris, and cleaning up thoroughly after the work is complete.
Homeowners can also take steps to ensure compliance and safety during renovations. They should hire only certified firms and contractors who follow lead-safe work practices. They should also ask for a copy of the firm’s certification and a description of the work to be performed. Homeowners should also ensure that all occupants, especially children and pregnant women, are kept away from the work area during renovations.
In summary, the RRP Rule is an important regulation that protects homeowners and their families from lead-based paint hazards during renovations. Compliance with the rule involves obtaining EPA certification and following lead-safe work practices. Homeowners should hire only certified firms and contractors and take steps to ensure the safety of all occupants during renovations.
Prevention and Maintenance

Preventing Lead Dust and Contamination
Prevention is key when it comes to lead paint safety. Homeowners should take necessary steps to prevent lead dust and contamination from forming. One way to do this is to keep the home clean and tidy. Regular cleaning of flat surfaces like window sills and floors can help reduce the amount of lead dust in the home. Homeowners should use a damp cloth or paper towel to wipe down surfaces weekly, and use a damp mop to clean smooth floors.
Another way to prevent lead dust and contamination is to repair any peeling or chipping paint as soon as possible. When paint starts to chip, it can create lead dust that can be harmful to inhale. Homeowners should also avoid using abrasive cleaning methods, such as sanding or dry scraping, as these methods can create lead dust.
Maintaining Lead-Safe Environments
Maintaining a lead-safe environment is important for the safety of all occupants in the home. Homeowners should ensure that all renovations, repairs, and painting jobs are done by a certified lead professional. These professionals are trained to work with lead-based paint safely and can help prevent the spread of lead dust during these types of projects.
Homeowners should also keep their home well-maintained to prevent any moisture problems that can cause paint to peel or chip. Moisture problems can cause lead-based paint to flake off, creating lead dust that can be harmful to inhale. Homeowners should also ensure that any lead hazards in the home are properly addressed by a certified lead professional.
In summary, homeowners can prevent lead dust and contamination by keeping their home clean and tidy, repairing any peeling or chipping paint, and avoiding abrasive cleaning methods. Maintaining a lead-safe environment is important, and homeowners should ensure that all renovations, repairs, and painting jobs are done by a certified lead professional. By following these tips, homeowners can stay safe and keep their home free from lead hazards.
Legal Responsibilities and Tenant Rights

When it comes to lead paint safety, both landlords and tenants have legal responsibilities. Landlords are obligated to disclose any known lead paint hazards to tenants, while tenants have the right to live in a safe and healthy environment free from lead hazards.
Landlord Obligations and Disclosure
Under federal law, landlords of residential properties built before 1978 must disclose any known lead paint hazards to tenants before they sign a lease. This includes providing tenants with the EPA-approved pamphlet “Protect Your Family from Lead in Your Home” and disclosing any known lead-based paint and hazards in the home.
In addition to federal law, some states and localities have their own lead paint disclosure requirements. For example, California requires landlords to disclose any known lead hazards in a rental unit, as well as provide tenants with a booklet on lead hazards.
Landlords are also required to maintain their rental properties in compliance with state and local housing codes, including ensuring that any lead paint hazards are properly addressed. Failure to do so can result in legal action against the landlord.
Tenant Rights and Legal Recourse
Tenants have the right to a safe and healthy living environment free from lead paint hazards. If a tenant believes that their rental unit contains lead hazards, they should notify their landlord in writing and request that the hazards be addressed.
If the landlord fails to address the lead hazards, tenants may have legal recourse. They can file a complaint with their state or local housing authority, or they can take legal action against the landlord for failing to provide a safe and habitable living environment.
Tenants should also be aware of their rights under state and federal law, including the right to sue a landlord for damages if they are injured as a result of lead paint exposure.
In conclusion, both landlords and tenants have legal responsibilities when it comes to lead paint safety. Landlords are required to disclose any known lead hazards and maintain their rental properties in compliance with state and local housing codes, while tenants have the right to live in a safe and healthy environment free from lead hazards. If a tenant believes that their rental unit contains lead hazards, they should notify their landlord in writing and take appropriate legal action if necessary.
Resources and Assistance
Homeowners concerned about the presence of lead-based paint in their homes can turn to various resources and assistance programs for help. This section will provide an overview of some of the most useful resources and assistance programs available to homeowners.
Government and State Programs
The Environmental Protection Agency (EPA) has a comprehensive website dedicated to lead-based paint safety. The website provides information on lead-based paint hazards, the Lead Renovation, Repair and Painting (RRP) Rule, and other important topics. Homeowners can also find information on how to find a certified lead-safe contractor in their area.
In addition to the EPA, many states have their own lead-based paint programs. These programs may offer assistance with testing for lead-based paint, financial assistance for lead abatement, and educational materials for homeowners. Homeowners can contact their state’s environmental or health department for more information on available programs.
Educational Material and Training
Homeowners can also find a wealth of educational materials and training programs on lead-based paint safety. The EPA offers online training courses for renovators, contractors, and other professionals who work with lead-based paint. The courses cover topics such as lead-safe work practices, health effects of lead exposure, and proper lead abatement techniques.
The National Lead Information Center (NLIC) is another valuable resource for homeowners. The NLIC offers a toll-free hotline for homeowners to call and ask questions about lead-based paint. The center also provides educational materials and referrals to local resources.
In conclusion, homeowners have many resources and assistance programs available to help them protect their families from the dangers of lead-based paint. By taking advantage of these resources and educating themselves on lead-based paint safety, homeowners can ensure that their homes are safe and healthy places to live.
Frequently Asked Questions
How can homeowners safely remove lead paint?
Homeowners should not attempt to remove lead paint themselves. Instead, they should hire a professional lead abatement contractor who is trained and certified in lead-safe work practices. Homeowners should also ensure that the contractor follows the appropriate guidelines for lead-safe work practices, including containment, ventilation, and cleanup procedures. Homeowners can find a certified lead abatement contractor through their state or local health department or by visiting the EPA’s website.
What are the health risks associated with lead paint in homes?
Lead paint in homes can pose serious health risks, especially to children under the age of six and pregnant women. Exposure to lead can cause developmental delays, learning disabilities, and other health problems. Homeowners should take steps to prevent exposure to lead paint, including regular cleaning and maintenance of painted surfaces, avoiding the use of abrasive cleaning methods, and ensuring proper ventilation during renovations.
Where can I obtain a free lead-based paint information pamphlet?
Homeowners can obtain a free lead-based paint information pamphlet from their local health department or by visiting the EPA’s website. The pamphlet provides information on the hazards of lead-based paint, how to identify it, and how to control it.
What are the guidelines for landlords to disclose lead paint hazards?
Landlords are required by law to disclose any known lead paint hazards to tenants before they sign a lease. Landlords must also provide tenants with a lead hazard information pamphlet and a copy of any lead inspection reports. Failure to disclose lead paint hazards can result in legal action against the landlord.
How can I test my home for lead-based paint?
Homeowners can test their home for lead-based paint by using a lead test kit, which can be purchased at most hardware stores. Homeowners should follow the instructions carefully and test all painted surfaces, including walls, ceilings, and trim. If lead-based paint is found, homeowners should contact a professional lead abatement contractor to safely remove it.
What precautions should be taken when renovating a house with lead paint?
When renovating a house with lead paint, homeowners should take the appropriate precautions to prevent exposure to lead dust and chips. This includes using containment methods, such as plastic sheeting, to isolate the work area, using appropriate ventilation to minimize dust, and using wet methods to minimize dust generation. Homeowners should also ensure that all workers are trained in lead-safe work practices and that they follow the appropriate guidelines for cleanup and disposal of lead-contaminated materials.